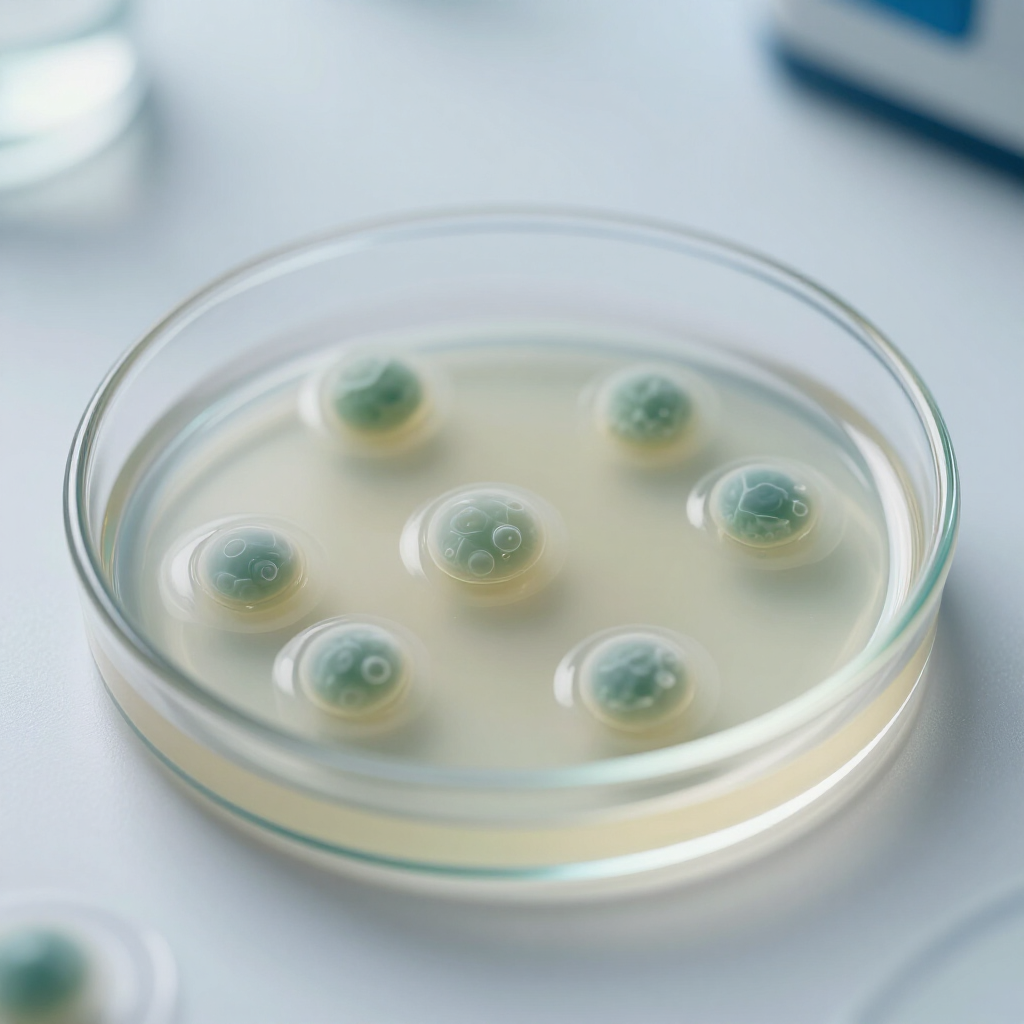

Innovating Drug Repurposing for Neglected Diseases
At ChukNova Inc., we harness the power of artificial intelligence to transform the landscape of drug repurposing. Our focus is on neglected diseases, where we identify new therapeutic potentials for existing medications, aiming to improve patient outcomes and enhance global health. Through cutting-edge technology and a dedicated team of experts, we are committed to making a significant impact in the biotech industry.
Features
AI-Driven Insights
Our advanced AI algorithms analyze vast datasets to identify potential drug repurposing opportunities, accelerating the development of treatments for neglected diseases.
Targeted Solutions
ChukNova focuses on diseases that have been overlooked, ensuring that our solutions address critical health challenges faced by underserved populations.
Collaborative Research
We partner with leading research institutions and healthcare organizations to validate our findings and enhance the efficacy of our drug repurposing strategies.
About ChukNova Inc.
ChukNova Inc. is at the forefront of biotechnology, specializing in AI-driven drug repurposing aimed at tackling neglected diseases. Our innovative approach leverages advanced artificial intelligence to identify new therapeutic uses for existing medications, significantly accelerating the drug development process. By focusing on diseases that often receive insufficient attention, we strive to make a meaningful impact on global health. Our dedicated team of experts combines deep scientific knowledge with cutting-edge technology to bring hope to underserved populations.
Who we work with
At ChukNova Inc., our dedicated team combines expertise in biotechnology and artificial intelligence to drive innovative solutions for neglected diseases. Each member plays a crucial role in our mission to repurpose existing drugs, ensuring that we make a meaningful impact on global health.
Meet Our Team
Testimonials

ChukNova's innovative approach to drug repurposing has significantly accelerated our research timelines. Their AI-driven solutions have opened new avenues for tackling neglected diseases, making a real difference in patient outcomes.
Dr. Emily Carter

Working with ChukNova has transformed our understanding of drug efficacy. Their expertise in AI technology has enabled us to identify promising treatments that were previously overlooked.
Professor Mark Thompson

The collaboration with ChukNova has been invaluable. Their commitment to addressing neglected diseases through advanced technology is commendable and has greatly enhanced our project outcomes.
Dr. Sarah Lee

ChukNova's team is not only knowledgeable but also passionate about their mission. Their innovative solutions have provided us with the tools needed to make a significant impact in the field of biotechnology.
Dr. James Patel
Photo Gallery
Frequently Asked Questions
What is drug repurposing?
Drug repurposing involves finding new uses for existing medications. This approach can accelerate the development of treatments for neglected diseases by leveraging existing safety data and mechanisms of action.
How does ChukNova Inc. utilize AI in drug repurposing?
ChukNova Inc. employs advanced AI algorithms to analyze vast datasets, identifying potential new applications for existing drugs. This technology enhances the efficiency and accuracy of the repurposing process.
What types of diseases does ChukNova focus on?
Our primary focus is on neglected diseases that often lack sufficient research funding and treatment options. We aim to address these critical health challenges through innovative drug repurposing strategies.
How can I get involved with ChukNova Inc.?
We welcome collaboration with researchers, healthcare professionals, and organizations interested in advancing treatments for neglected diseases. Please contact us through our website for partnership opportunities.


Innovative Solutions for Neglected Diseases
ChukNova Inc. leverages cutting-edge AI technology to identify new uses for existing drugs, targeting neglected diseases that often lack sufficient research and funding. Our mission is to transform healthcare outcomes for underserved populations through efficient and effective drug repurposing.
Let's talk!
Business Hours
- Mon - Fri
- -
- Sat - Sun
- Closed
611 South Dupont Highway, Dover, DE 19901-4507, US
Custom Address Details
Contact Us
Thank you for contacting us. We will get back to you as soon as possible.
Oops, there was an error sending your message.
Please try again later.
Please try again later.